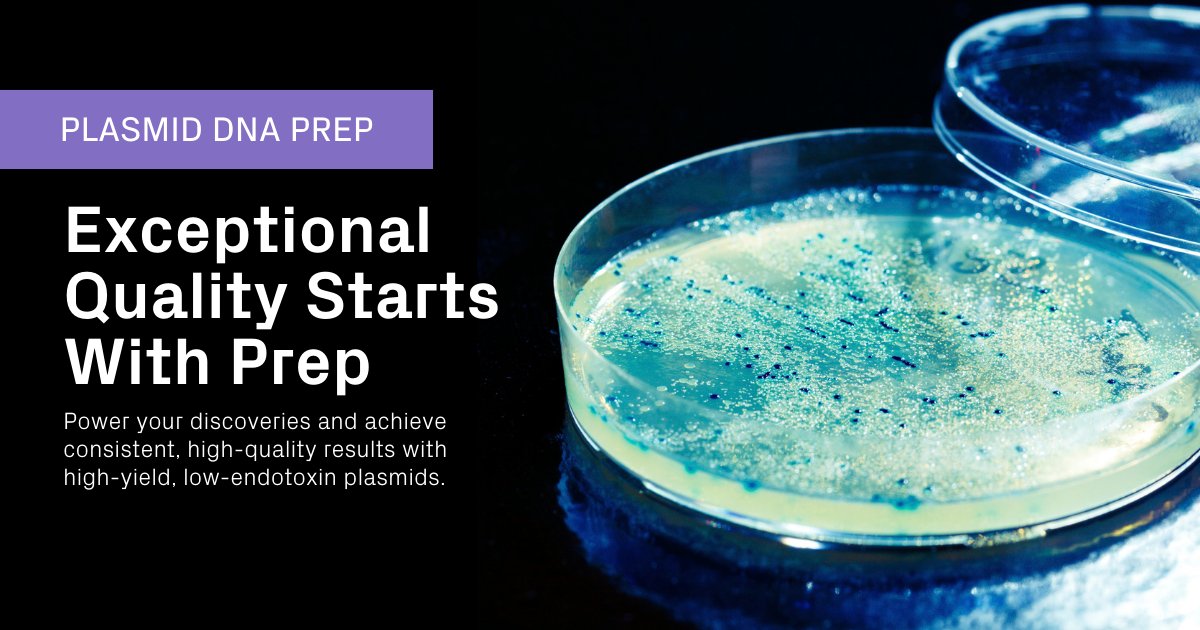
AzentaSciences's tweet image. Enhance your research with our high-yield, low-endotoxin #PlasmidPrep. Enjoy consistent and reliable results that empower your discoveries. Explore now: hubs.ly/Q02_Bqft0

#PlasmidPrep #DNAPrep

#dnaprep search results
Darrellreon (Reece) Morris is playing up with the high school division 9th and 10th graders he did alright,,, but he is in the 7th grade, and we are a long way away still have a lot to work too do. #wcetop100camp #DNAprep @Get_Money_Mike @ll2_tt
Look at who just arrived on the GeT-PlaGe platform! @SptLabTech's Mosquito - a plus for pipetting at least 500 nL to reduce the DNA input and cost of @Illumina #DNAprep libraries👍 #SeqOccIn

rPeptide offers a full array of contract services. Our scientists can assist with DNA preparation, protein expression, fermentation, purification, and #lyophilization. Let us know how we can help with your next project. #DNAprep #cloningservices #proteinpurification

Grind Session #1 COACH'S Arizona Athletic Grounds Friday 3pm vs Elite Prep(Az) (Court #6) Saturday 2pm vs Paragom Academy (Court #5) 5pm vs Abc Prep (Red) (Court #2) Sunday 1130am vs Tap (Court #6) #TeamDevelop #DNAPREP



Enhance your research with our high-yield, low-endotoxin #PlasmidPrep. Enjoy consistent and reliable results that empower your discoveries. Explore now: hubs.ly/Q02_Bqft0 #PlasmidPrep #DNAPrep

Accelerate your research with our fast #PlasmidPrep service - delivery in just two days! Enjoy free shipping via our dropbox and courier network. Streamline your workflow: hubs.ly/Q02_Bq9X0 #PlasmidPrep #DNAPrep

The @Earlham Institute worked with us to build a brand new miniaturized Illumina DNA Prep method using our next generation platform firefly. Watch the whole webinar to find out more - bit.ly/3VggUuZ #illumina #dnaprep #labautomation

Transform your maxi-scale plasmid purification workflow today with the AmMag™ Quatro! 🚀🤖 Revolutionize your plasmid prep with the AmMag™ Quatro! Discover how Ms. Lu Lu from Incyte achieved peak efficiency in their lab: bit.ly/4cMGekh #DNAprep #AmMagQuatro #AmMag

We're proud to announce that SPT Labtech has been named an Illumina Qualified Methods Developer, following the successful automation of Illumina DNA Prep on our firefly® platform! Learn more: go.sptlabtech.com/40iD7N4 #LabAutomation #NGS #DNAprep #librarypreparation

Wake Up Everyone Please Pay Attention…Jayden Robinson is one the Next Big Time Players that will come out of Southern California! He’s a 14 year old 6’3” Combo Guard in Class 2028 that can play all Skill Positions on the Court! #HeGotNext #DNAPrep @dstrktacademy
Experience faster turnaround times and high-quality pDNA with GenScript’s AmMag™ Quatro! Ms. Lu Lu from Incyte shares her experience using the automated plasmid Maxi-prep solution, GenScript’s AmMag™ Quatro: bit.ly/4cMGekh #DNAprep #AmMagQuatro #AmMag

Jayden Robinson is one of the Most Skilled Freshman in America….Stevie Wonder can see THIS!!!! 😈 #DNAPrep @IamFR5 @NikeEYB
Preparing the DNA samples is a crucial step for a successful digital PCR experiment. Learn about the important parameters to keep in mind for optimal DNA samples here: gene-pi.com/item/dna-prepa… #digitalPCR #genepilearningcenter #DNAprep

Scouts & College Coaches around the Country, please pay attention to my young Fella right Here, Jayden Robinson 6’3” CG in Class of 2028, he plays for #DNAPrep at @dstrktacademy in Cali This Kid #GotNext & he plays the Right Way….#CoachesDream More Than #25YearsNoAirBalls

Love 'Ralph Day'. PHS students are lucky to have such supportive community member. #DNAprep #vortex #biologyrevolution
❤️🎙️Thanks Ms. Lu from Incyte, for the 5-star review of GenScript’s AmMag™ Quatro and support team! 🎙️ ❤️Discover why the AmMag™ Quatro stood out as the fully automatic solution for maxi-scale plasmid purification. #DNAprep #AmMagQuatro
Grind Session #1 COACH'S Arizona Athletic Grounds Friday 3pm vs Elite Prep(Az) (Court #6) Saturday 2pm vs Paragom Academy (Court #5) 5pm vs Abc Prep (Red) (Court #2) Sunday 1130am vs Tap (Court #6) #TeamDevelop #DNAPREP



We're proud to announce that SPT Labtech has been named an Illumina Qualified Methods Developer, following the successful automation of Illumina DNA Prep on our firefly® platform! Learn more: go.sptlabtech.com/40iD7N4 #LabAutomation #NGS #DNAprep #librarypreparation

Jayden Robinson is one of the Most Skilled Freshman in America….Stevie Wonder can see THIS!!!! 😈 #DNAPrep @IamFR5 @NikeEYB
2027 G Jaylin Conard (@Conard1Jaylin) of DNA Prep Academy (CA) is making waves, averaging 18.5 PPG and 4.6 APG in The Grind Session Conard is averaging 17 PPG & 5.9 APG through 25 games overall. With 425 points and 147 assists, Conard’s shifty, tough playmaking skills and…

THESE BOYS GOOD MAN!!!! #WestCoast #DNAPrep @conrad1Jaylin @kingjayrob5
The best young backcourt in the country was at it again last night in a game against Top 5 Ranked Prolific Prep ‘28 G Jayden Robinson finished with 14 PTS, 4 AST, 3 STL, and 4 REB while being guard by Kansas signee Darryn Peterson. Robinson showcased his elite skill set and…
Scouts & College Coaches around the Country, please pay attention to my young Fella right Here, Jayden Robinson 6’3” CG in Class of 2028, he plays for #DNAPrep at @dstrktacademy in Cali This Kid #GotNext & he plays the Right Way….#CoachesDream More Than #25YearsNoAirBalls

Best Young Backcourt In America and They Not Even Close to being Fully Developed! #TheyGotNext #DSTRKT #DNAPrep
One of the youngest back courts in the nation has made a splash this season during @thegrindsession C/O ‘28 G Jayden Robinson and C/O ‘27 G Jaylin Conard have led DNA Prep Academy with their scoring and passing abilities This young duo is on the rise and will continue to open…


Coaches and Scouts, PLEASE pay attention to his Name, make friends with this Kid NOW while you can….Jayden Robinson 6’3” CG #DNAPrep Class 2028 #HeGotNext 😈
14 years old! Put us on his back this weekend. 20ppg 4rpg 4.5apg 2.5spg 11-16 from 3pt @MEdwardsBball

Wake Up Everyone Please Pay Attention…Jayden Robinson is one the Next Big Time Players that will come out of Southern California! He’s a 14 year old 6’3” Combo Guard in Class 2028 that can play all Skill Positions on the Court! #HeGotNext #DNAPrep @dstrktacademy
Streamline your workflow with our scalable #PlasmidPrep solutions! From colony sequencing to 5g plasmids, get results in as little as two business days. Enhance your research efficiency today: hubs.ly/Q02_BqlT0 #PlasmidPrep #DNAPrep
Accelerate your research with our fast #PlasmidPrep service - delivery in just two days! Enjoy free shipping via our dropbox and courier network. Streamline your workflow: hubs.ly/Q02_Bq9X0 #PlasmidPrep #DNAPrep

Enhance your research with our high-yield, low-endotoxin #PlasmidPrep. Enjoy consistent and reliable results that empower your discoveries. Explore now: hubs.ly/Q02_Bqft0 #PlasmidPrep #DNAPrep

Struggling with purifying large-scale plasmid manually? The AmMag™ Quatro will be your best solution! 🚀 Hear from Dr. Zhu and discover how the AmMag™ Quatro changes their day-to-day workflow and boosts their lab's productivity. #GenScriptProducts #DNAprep #AmMagQuatro
❤️🎙️Thanks Ms. Lu from Incyte, for the 5-star review of GenScript’s AmMag™ Quatro and support team! 🎙️ ❤️Discover why the AmMag™ Quatro stood out as the fully automatic solution for maxi-scale plasmid purification. #DNAprep #AmMagQuatro
💌 “We love this solution!” Dr. Zhu’s team said, after using the AmMag™ Quatro, an automated plasmid maxi-prep solution. 💌 🌐 Discover how GenScript’s 𝗔𝗺𝗠𝗮𝗴™ 𝗤𝘂𝗮𝘁𝗿𝗼 can save time and reduce costs for Dr. Zhu’s lab. #DNAprep #AmMagQuatro #LabEfficiency #maxiprep
Experience faster turnaround times and high-quality pDNA with GenScript’s AmMag™ Quatro! Ms. Lu Lu from Incyte shares her experience using the automated plasmid Maxi-prep solution, GenScript’s AmMag™ Quatro: bit.ly/4cMGekh #DNAprep #AmMagQuatro #AmMag

rPeptide offers a full array of contract services. Our scientists can assist with DNA preparation, protein expression, fermentation, purification, and #lyophilization. Let us know how we can help with your next project. #DNAprep #cloningservices #proteinpurification

Enhance your research with our high-yield, low-endotoxin #PlasmidPrep. Enjoy consistent and reliable results that empower your discoveries. Explore now: hubs.ly/Q02_Bqft0 #PlasmidPrep #DNAPrep
Look at who just arrived on the GeT-PlaGe platform! @SptLabTech's Mosquito - a plus for pipetting at least 500 nL to reduce the DNA input and cost of @Illumina #DNAprep libraries👍 #SeqOccIn

Accelerate your research with our fast #PlasmidPrep service - delivery in just two days! Enjoy free shipping via our dropbox and courier network. Streamline your workflow: hubs.ly/Q02_Bq9X0 #PlasmidPrep #DNAPrep

Transform your maxi-scale plasmid purification workflow today with the AmMag™ Quatro! 🚀🤖 Revolutionize your plasmid prep with the AmMag™ Quatro! Discover how Ms. Lu Lu from Incyte achieved peak efficiency in their lab: bit.ly/4cMGekh #DNAprep #AmMagQuatro #AmMag

Experience faster turnaround times and high-quality pDNA with GenScript’s AmMag™ Quatro! Ms. Lu Lu from Incyte shares her experience using the automated plasmid Maxi-prep solution, GenScript’s AmMag™ Quatro: bit.ly/4cMGekh #DNAprep #AmMagQuatro #AmMag

The @Earlham Institute worked with us to build a brand new miniaturized Illumina DNA Prep method using our next generation platform firefly. Watch the whole webinar to find out more - bit.ly/3VggUuZ #illumina #dnaprep #labautomation

We're proud to announce that SPT Labtech has been named an Illumina Qualified Methods Developer, following the successful automation of Illumina DNA Prep on our firefly® platform! Learn more: go.sptlabtech.com/40iD7N4 #LabAutomation #NGS #DNAprep #librarypreparation

Preparing the DNA samples is a crucial step for a successful digital PCR experiment. Learn about the important parameters to keep in mind for optimal DNA samples here: gene-pi.com/item/dna-prepa… #digitalPCR #genepilearningcenter #DNAprep

Scouts & College Coaches around the Country, please pay attention to my young Fella right Here, Jayden Robinson 6’3” CG in Class of 2028, he plays for #DNAPrep at @dstrktacademy in Cali This Kid #GotNext & he plays the Right Way….#CoachesDream More Than #25YearsNoAirBalls

Something went wrong.
Something went wrong.
United States Trends
- 1. GeForce Season 3,971 posts
- 2. Comey 185K posts
- 3. Everton 144K posts
- 4. St. John 8,716 posts
- 5. Mark Kelly 123K posts
- 6. Amorim 61.5K posts
- 7. Manchester United 84K posts
- 8. Iowa State 3,515 posts
- 9. #sjubb N/A
- 10. Seton Hall 2,330 posts
- 11. UCMJ 18.3K posts
- 12. Opus 4.5 9,048 posts
- 13. Pickford 11.2K posts
- 14. Benedict Arnold 3,926 posts
- 15. 49ers 19.5K posts
- 16. #LightningStrikes N/A
- 17. Dealing 31.4K posts
- 18. Genesis Mission 1,914 posts
- 19. Hegseth 48.2K posts
- 20. Halligan 56.4K posts












